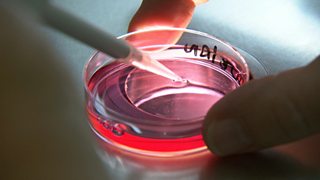

- All
- Available now (0)
- Next on (0)
-
![]()
Episode 24
24/24 Reporting on the most interesting stories from around Europe.
-
![]()
Episode 23
23/24 Reporting on the most interesting stories from around Europe.
-
![]()
Episode 22
22/24 Reporting on the most interesting stories from around Europe.
-
![]()
Episode 21
21/24 Reporting on the most interesting stories from around Europe.
-
![]()
Episode 20
20/24 Reporting on the most interesting stories from around Europe.
-
![]()
Episode 19
19/24 Reporting on the most interesting stories from around Europe.
-
![]()
Episode 18
18/24 Reporting on the most interesting stories from around Europe.
-
![]()
Episode 17
17/24 Reporting on the most interesting stories from around Europe.
-
![]()
Episode 16
16/24 Darren Laing looks back at stories the team has covered on religious subjects.
-
![]()
Episode 15
15/24 Roddy Munro looks back through the Eorpa archive.
-
![]()
Episode 14
14/24 Iain MacInnes looks through the Eorpa archive at stories on the history of Europe.
-
![]()
Episode 13
13/24 Reporting on the most interesting stories from around Europe.
-
![]()
Episode 12
12/24 Reporting on the most interesting stories from around Europe.
-
![]()
Episode 11
11/24 Reporting on the most interesting stories from around Europe.
-
![]()
Episode 10
10/24 Reporting on the most interesting stories from around Europe.
-
![]()
Episode 9
9/24 A look back through the Eorpa archive at stories about divided communities in Europe.
-
![]()
Episode 8
8/24 Iain Macinnes looks back through the Eorpa archive at stories about languages in Europe.
-
![]()
Episode 7
7/24 Reporting on the most interesting stories from around Europe.
-
![]()
Episode 6
6/24 蜜芽传媒 Scotland's weekly Gaelic current affairs programme. With English subtitles.
-
![]()
Episode 5
5/24 Reporting on the most interesting stories from around Europe.
-
![]()
Episode 4
4/24 Reporting on the most interesting stories from around Europe.
-
![]()
Episode 3
3/24 Reporting on the most interesting stories from around Europe.
-
![]()
Episode 2
2/24 Reporting on the most interesting stories from around Europe.
-
![]()
Episode 1
1/24 Reporting on the most interesting stories from around Europe.